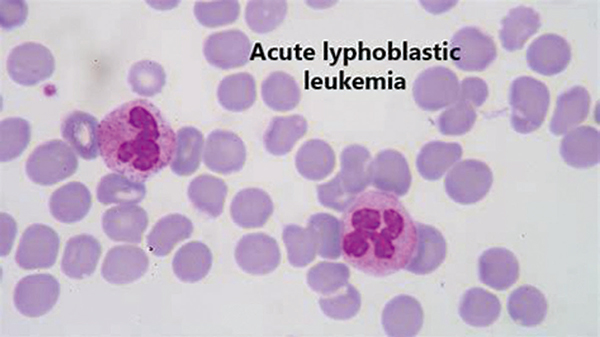

婴儿 ALL 诱导后 MRD 水平可指导巩固方案的选择
荷兰研究者Stutterheim等报告,诱导治疗可甄选婴儿急性淋巴细胞白血病(ALL)患者,诱导结束时最小残留疾病(MRD)水平高者可自髓样巩固方案中获益,水平低者可自淋巴样巩固方案中获益。(J Clin Oncol. 2021年1月6日在线版 DOI: 10.1200/JCO.20.02333)
婴儿ALL以KMT2A基因重排率高为特征,且预后差。为了明确Interfant-06方案中KMT2A重排ALL患儿MRD的价值,该研究比较了淋巴样巩固方案(方案ⅠB)与髓样巩固方案(araC,柔红霉素,依托泊苷/米托蒽醌,araC,依托泊苷)。在诱导结束(EOI)和巩固结束(EOC)时,249例患病婴儿的MRD由DNA聚合酶链反应检测KMT2A重排、免疫球蛋白和(或)T细胞受体基因而得出。MRD结果分为阴性、中等水平(<5×10-4)和高水平(≥5×10-4)。
结果显示,EOI MRD水平可预测6年的无病生存(DFS)率,其中MRD阴性、中等水平和高水平患儿的6年DFS率分别为60.2%(95%CI 43.2%~73.6%)、45.0%(95%CI 28.3%~53.1%)和33.8%(95%CI 23.8%~44.1%,P=0.0039)。EOC MRD水平也可预测结局,MRD阴性、中等水平和高水平患儿的6年DFS率分别为68.2%(95%CI 55.2%~78.1%)、40.1%(95%CI 28.1%~51.9%)和11.9%(95%CI 2.6%~29.1,P<0.0001)。
根据巩固治疗类型进行的EOI MRD分析显示,淋巴样巩固方案在MRD阴性、中等水平和高水平患儿中的6年DFS率分别为78.2%(95%CI 51.4%~91.3%)、47.2%(95%CI 33.0%~60.1%)和23.2%(95%CI 12.1%~36.4%,P<0.0001),而髓样巩固方案者的分别为45.0%(95%CI 23.9%~64.1%)、41.3%(95%CI 23.2%~58.5%)和45.9%(95%CI 29.4%~60.9%)。
(编译 毛振泉)


